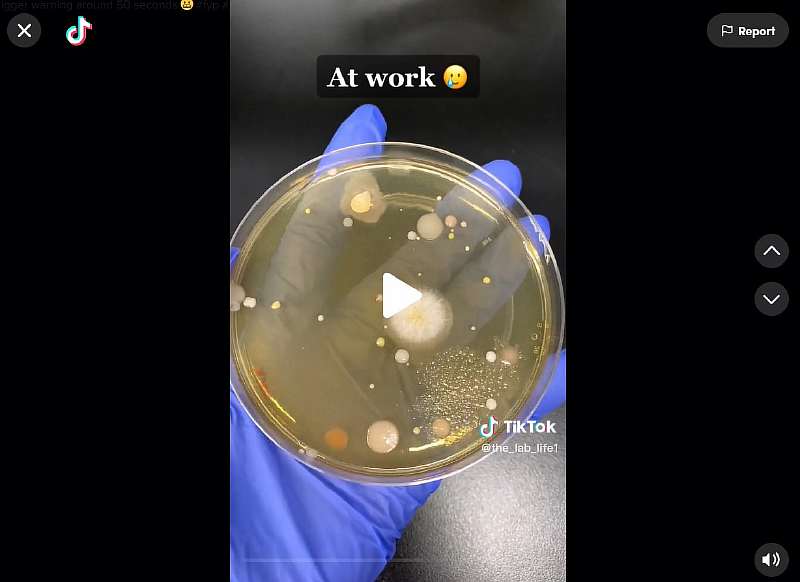

После этого у вас пропадет желание снова пользоваться сушилкой для рук
Сушилки для рук — привычный элемент почти любого общественного туалета. На первый взгляд, эти устройства кажутся вполне удобными и гигиеничными, ведь они избавляют от необходимости лишний раз к чему-то прикасаться. Однако это впечатление обманчиво, а сами сушилки могут оказаться куда опаснее, чем вы думаете.
По сети разлетелся ролик от тиктокерши @the_lab_life1, которая провела любопытный эксперимент. Девушка взяла чашки Петри и подставила их под поток воздуха из сушилок для рук в различных общественных местах: в торговом центре, кинотеатре, на работе, а затем изучила образцы.

Оказалось, что все 3 образца содержат потенциально опасные для человека микроорганизмы. Как же так вышло? Дело в том, что сушилки забирают воздух из помещения, заодно собирая и бактерии с грязных поверхностей, а затем выдают их вместе с концентрированным потоком прямо людям на руки.
Какие именно бактерии были в образцах, ролик умалчивает. Но другие эксперименты по оценке чистоты общественных туалетов свидетельствуют, что в подобных местах можно наткнуться даже на гепатит и кишечную палочку.
И вряд ли вы захотите, чтобы нечто подобное оказалось у вас на руках. Так что сушилок для рук лучше избегать. Безопаснее не вытирать руки вообще или пользоваться бумажными салфетками.
@the_lab_life1 Trigger warning around 50 seconds ? #fyp #science #lab ♬ Dog Days Are Over — Florence + The Machine
Подписывайтесь на наш Telegram, чтобы не пропустить крутые статьи
Группа Geekville Вконтакте со всем актуальным контентом













